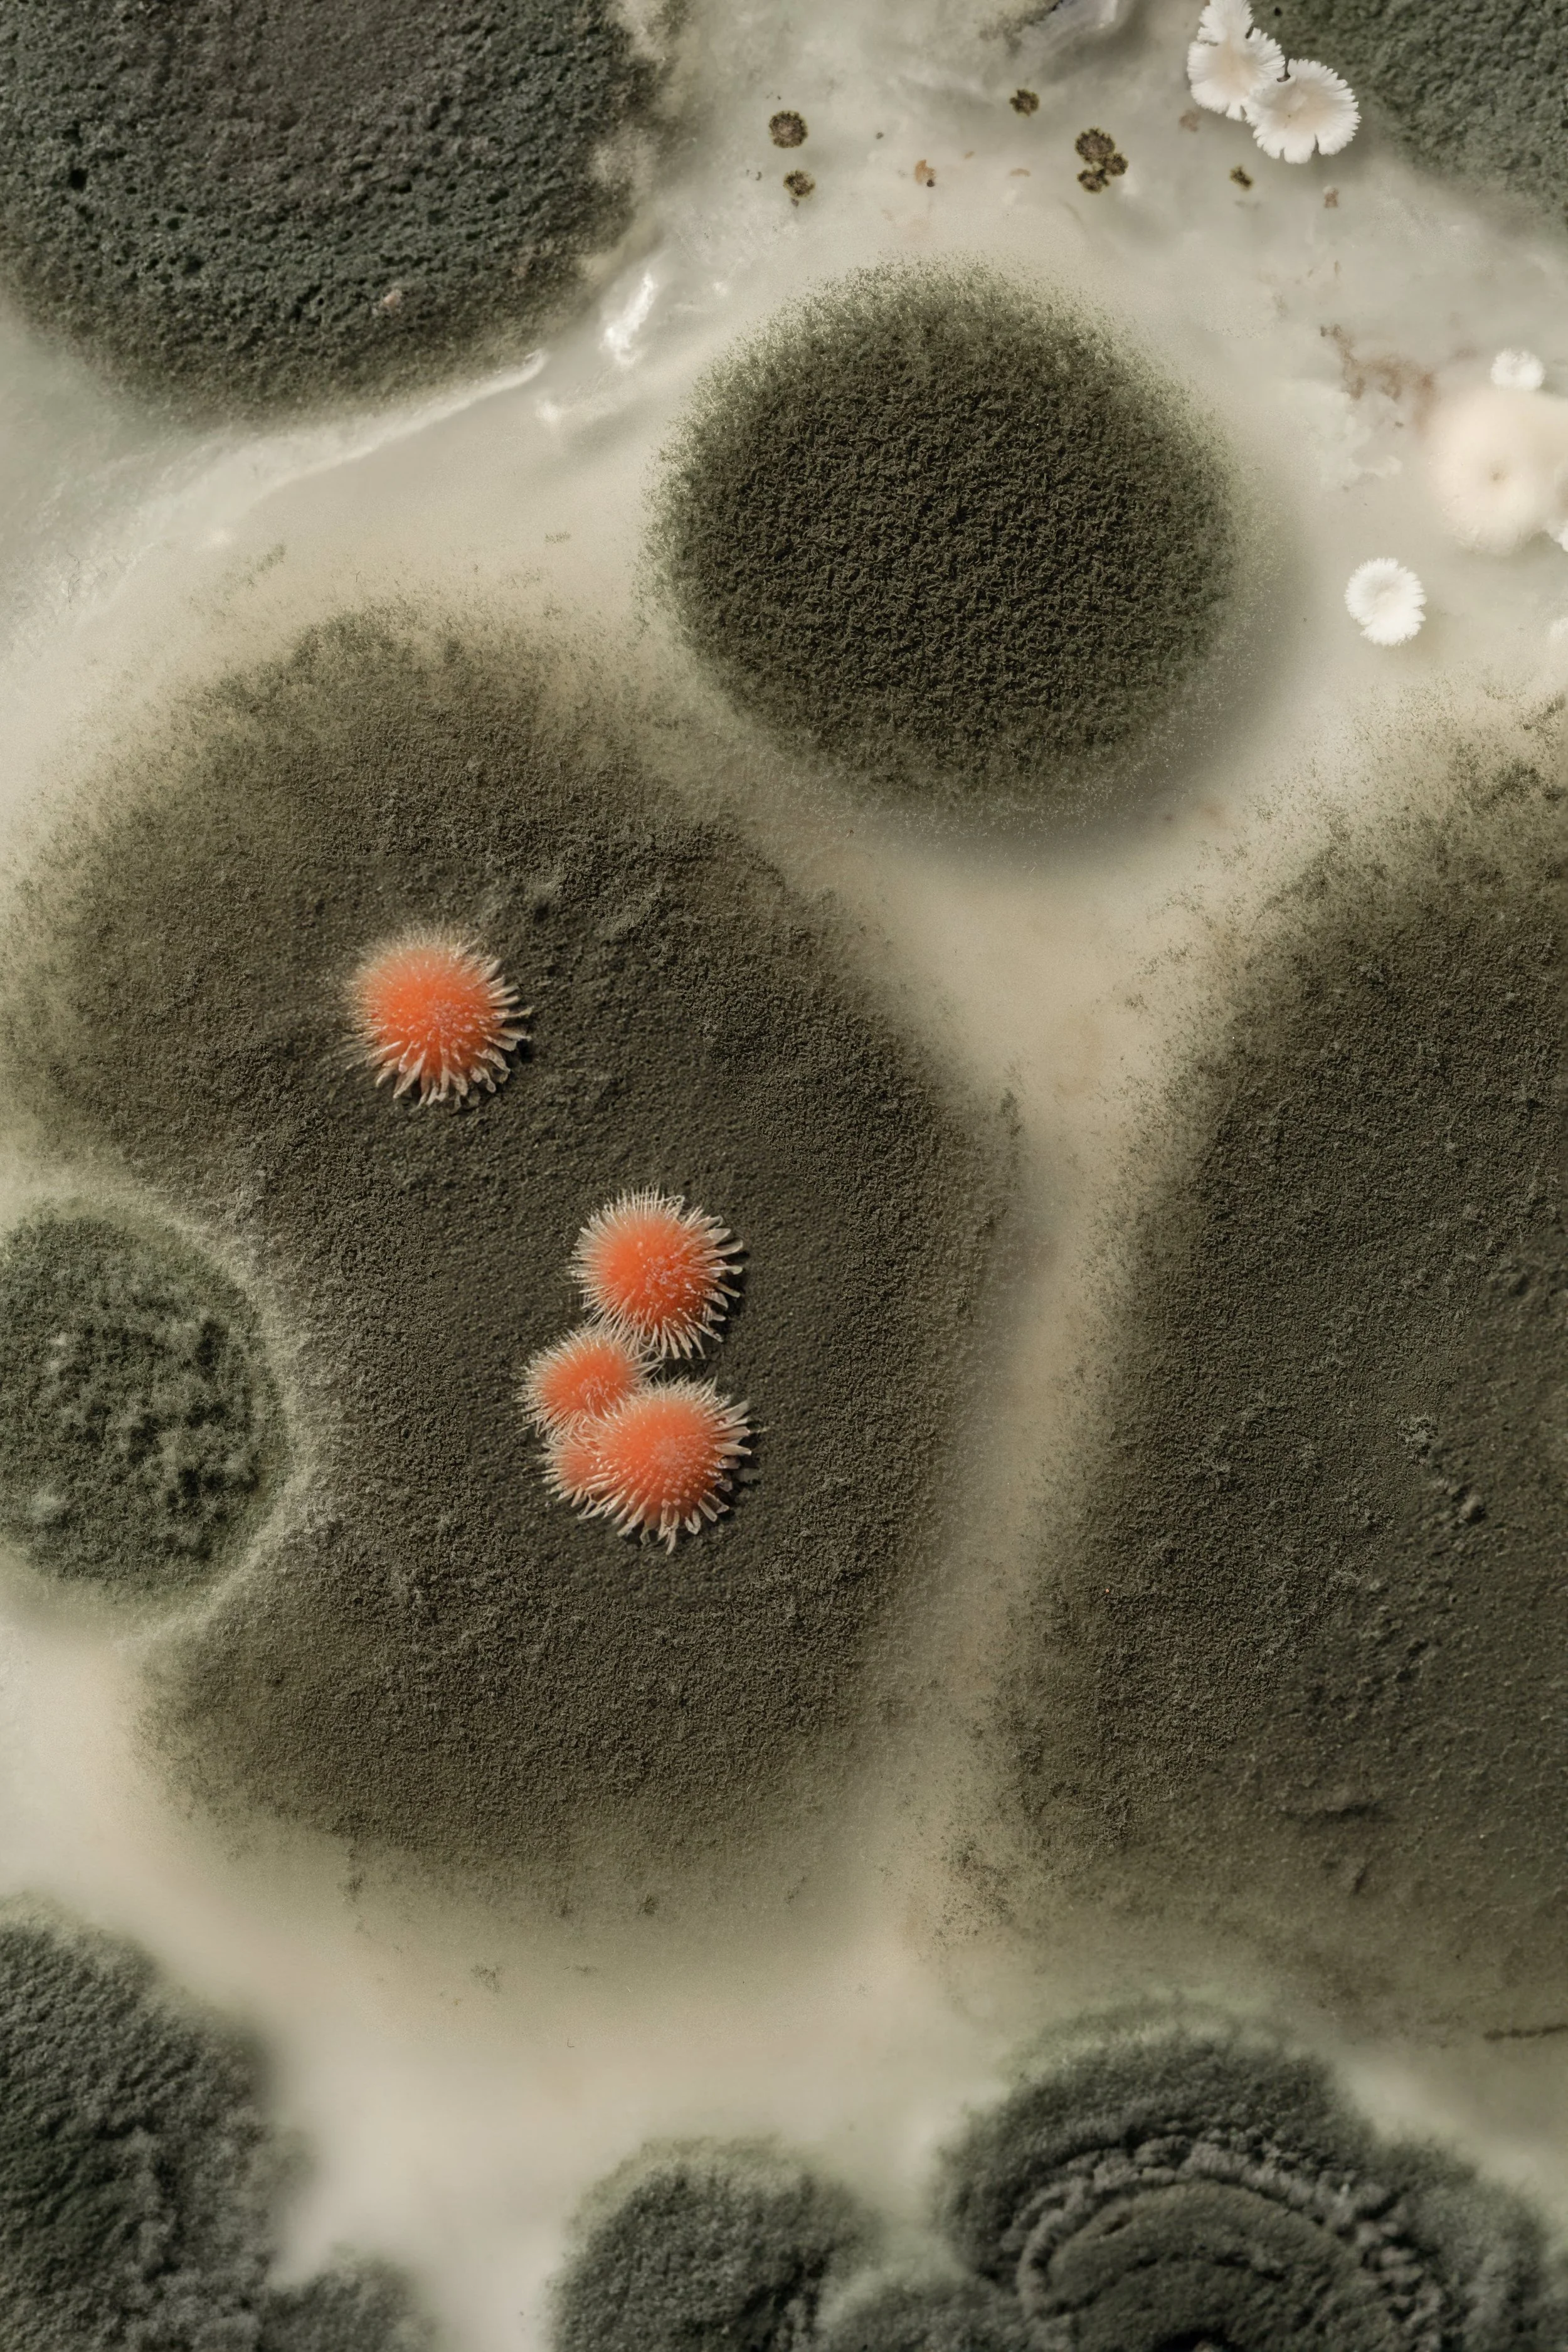

Science
My biomedical science expertise spans the translational
research pipeline.

Training in bench science, clinical research, and regulatory affairs lends a unique and well-rounded perspective of the research life cycle including experimental design, grant writing and manuscript preparation, clinical trial management, and post-market assessment.

Through my design company, I have partnered with healthcare organizations, startups, and community groups to transform complex scientific and clinical concepts into accessible, compelling narratives that foster engagement and improve health literacy.


My strengths encompass intentional knowledge dissemination, integrating science communication and graphic design to translate complex topics into accessible and actionable information through written and visual media.






My Education
Doctor of Philosophy, Neuroscience | Uniformed Services University, Mayo Clinic | 2023
Master of Business Administration, Regulatory Science | University of St. Thomas | 2014
Bachelor of Science, Biology | University of Colorado | 2010
Bachelor of Science, Chemistry | University of Colorado | 2010
Let’s work together